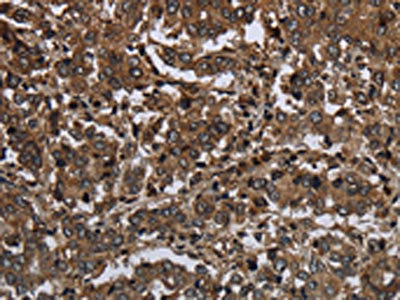

GLIPR1 Antibody
-
中文名稱:GLIPR1兔多克隆抗體
-
貨號:CSB-PA962337
-
規(guī)格:¥1100
-
圖片:
-
The image on the left is immunohistochemistry of paraffin-embedded Human liver cancer tissue using CSB-PA962337(GLIPR1 Antibody) at dilution 1/50, on the right is treated with fusion protein. (Original magnification: ×200)
-
The image on the left is immunohistochemistry of paraffin-embedded Human brain tissue using CSB-PA962337(GLIPR1 Antibody) at dilution 1/50, on the right is treated with fusion protein. (Original magnification: ×200)
-
-
其他:
產(chǎn)品詳情
-
Uniprot No.:
-
基因名:GLIPR1
-
別名:CRISP 7 antibody; CRISP7 antibody; GLI pathogenesis related 1 antibody; GLI pathogenesis-related 1 (glioma) antibody; Glioma pathogenesis related protein 1 antibody; Glioma pathogenesis-related protein 1 antibody; GLIP1_HUMAN antibody; GliPR 1 antibody; GLIPR antibody; GLIPR1 antibody; Protein RTVP-1 antibody; RELATED TO TESTIS SPECIFIC; VESPID; AND PATHOGENESIS PROTEINS 1 antibody; RTVP 1 antibody; RTVP1 antibody; Testes specific vespid and pathogenesis protein 1 antibody; testes-specific vespid and pathogenesis protein 1 antibody
-
宿主:Rabbit
-
反應(yīng)種屬:Human
-
免疫原:Fusion protein of Human GLIPR1
-
免疫原種屬:Homo sapiens (Human)
-
標(biāo)記方式:Non-conjugated
-
抗體亞型:IgG
-
純化方式:Antigen affinity purification
-
濃度:It differs from different batches. Please contact us to confirm it.
-
保存緩沖液:-20°C, pH7.4 PBS, 0.05% NaN3, 40% Glycerol
-
產(chǎn)品提供形式:Liquid
-
應(yīng)用范圍:ELISA,IHC
-
推薦稀釋比:
Application Recommended Dilution ELISA 1:2000-1:10000 IHC 1:100-1:300 -
Protocols:
-
儲存條件:Upon receipt, store at -20°C or -80°C. Avoid repeated freeze.
-
貨期:Basically, we can dispatch the products out in 1-3 working days after receiving your orders. Delivery time maybe differs from different purchasing way or location, please kindly consult your local distributors for specific delivery time.
-
用途:For Research Use Only. Not for use in diagnostic or therapeutic procedures.
相關(guān)產(chǎn)品
靶點詳情
-
基因功能參考文獻(xiàn):
- Data found that GLIPR1 expression level was low in human bladder cancer tissues. Also, GLIPR1 was shown to inhibit the expression of TPX2. PMID: 28799673
- High GLIPR1 expression is associated with cisplatin resistance in lung cancer. PMID: 28771580
- The present study identified GLIPR1 and miR-16 as key components for regulating the proliferation, migration, invasion and cancer-initiating cells in osteosarcoma PMID: 27460987
- This study reveals a novel pathway that PRMT5/WDR77 regulates GLIPR1 expression to control lung cancer cell growth. PMID: 26988096
- Overexpression of RTVP-1 in human neural stem cells induced mesenchymal differentiation, whereas silencing of RTVP-1 in glioma stem cells (GSCs) decreased the mesenchymal transformation and stemness of these cells. PMID: 26267319
- RTVP-1 regulates glioma cell spreading, migration and invasion and that these effects are mediated via interaction with N-WASP and by interfering with the inhibitory effect of hnRNPK on the function of this protein. PMID: 26305187
- Data indicate that combining adenoviral vector-mediated GLIPR1 gene therap (AdGLIPR1) with radiotherapy may achieve additive or synergistic tumor control in selected prostate and bladder tumors. PMID: 23433894
- Based on the observed overexpression in AML samples, GliPR1 should be further explored as a potential target for AML PMID: 24008279
- miR-137 inhibits Glioblastom stem cell self-renewal and promotes their differentiation by targeting RTVP-1 which down-regulates CXCR4. PMID: 23714687
- GLIPR1 interacts with Hsc70, and GLIPR1 overexpression or Hsc70 knockdown leads to transcriptional suppression of AURKA and TPX2. PMID: 23333597
- GLIPR1 core structure has a conserved central cavity via which CAP proteins are likely to bind to shared ligands. PMID: 21931216
- Data show that the expression of GLIPR1 and c-Myc were inversely correlated in prostate cancer. PMID: 22025562
- RTVP-1 plays a role in the effect of serum response factor on glioma cell migration PMID: 21777672
- demonstrate that GLIPR1 is a methylation-silenced gene in the acute myeloid leukemia patients PMID: 21922325
- GLIPR1 expression is downregulated or even lost by promoter methylation in acute myeloid leukemia. PMID: 19483285
- X-ray data have been collected to beyond 1.9 A resolution from a crystal of GLIPR1 that belonged to the orthorhombic space group P2(1)2(1)2 with average unit-cell parameters a = 85.1, b = 79.5, c = 38.9 A and either a monomer or dimer PMID: 21045302
- Induction of GliPR expression by HIV-1 was confirmed in P4-CCR5 cells. PMID: 20356381
- Expression of the human RTVP-1 gene is down-regulated in human prostate cancer specimens compared with normal human prostate tissue at the mRNA and protein levels. PMID: 14871827
- In this study we report the identification and characterization of a novel p53 target gene cluster that includes human RTVP1 (hRTVP-1) together with two GLIPR1L genes (GLIPR1L1 and GLIPR1L2) on human chromosome 12q21 and mouse Rtvp1 PMID: 16714093
- RTVP-1b is a novel splice variant of human RTVP-1, which was isolated from the U87 glioma cell line PMID: 17825796
- a role for GLIPR1/RTVP-1 deregulation early in Wilms tumorigenesis. PMID: 18030365
- GLIPR1 is a proapoptotic tumor suppressor acting through the ROS-JNK pathway. PMID: 18199537
顯示更多
收起更多
-
亞細(xì)胞定位:Membrane; Single-pass membrane protein.
-
蛋白家族:CRISP family
-
組織特異性:According to PubMed:8973356, it is ubiquitously expressed with high levels in lung and kidney and low levels in heart and liver. Highly expressed in cell lines derived from nervous system tumors arising from glia, low or absent in non-glial-derived nervou
-
數(shù)據(jù)庫鏈接:
Most popular with customers
-
-
YWHAB Recombinant Monoclonal Antibody
Applications: ELISA, WB, IHC, IF, FC
Species Reactivity: Human, Mouse, Rat
-
Phospho-YAP1 (S127) Recombinant Monoclonal Antibody
Applications: ELISA, WB, IHC
Species Reactivity: Human
-
-
-
-
-